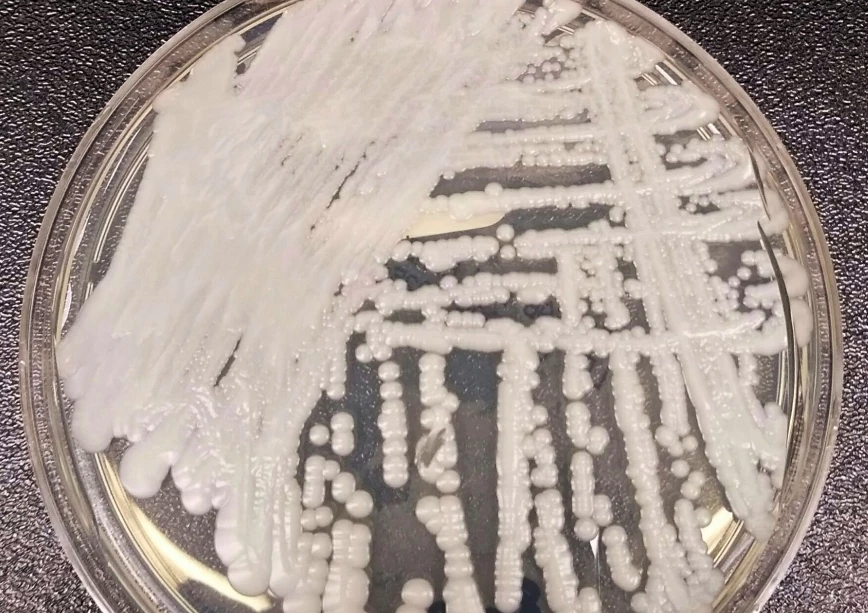

Τέλος στις ΜΕΘ για κοροναϊό – Η εισήγηση της Επιτροπής Εμπειρογνωμόνων
Πλέον οι εντατικές στα νοσοκομεία δεν θα διαχωρίζονται σε Covid-19 και non Covid και οι ασθενείς με

Πλέον οι εντατικές στα νοσοκομεία δεν θα διαχωρίζονται σε Covid-19 και non Covid και οι ασθενείς με

Μεγαλύτερα και πιο λειτουργικά πεζοδρόμια – Ας απομακρυνθούν επιτέλους οι άχρηστοι πλέον τηλεφωνικοί θάλαμοι. Οι πολίτες δικαιούνται

Το Υπουργείο Υγείας σε συνεργασία με το Πανεπιστήμιο Δυτικής Αττικής (ΠΑΔΑ) σχεδίασε το Εθνικό Πρόγραμμα Πρόληψης και Καταπολέμησης Παχυσαρκίας Ενηλίκων.

Με παρέμβασή του προς το Υπουργείο Υποδομών και Μεταφορών, ο Βουλευτής Δωδεκανήσου, κ. Μάνος Κόνσολας, ζητά την

Σύσκεψη με αντικείμενο ζητήματα της Μυκόνου πραγματοποιήθηκε στο Μέγαρο Μαξίμου υπό τον Πρωθυπουργό Κυριάκο Μητσοτάκη. «Δεν νοείται να υπάρχει ένα

Πολλά υποσχόμενο αποδείχτηκε κατά του καρκίνου το πειραματικό φάρμακο Revumenib σε πρώιμη κλινική δοκιμή για την θεραπεία δύο τύπων

Η 25η Μαρτίου, η οποία φέτος πέφτει Σάββατο έχει καθοριστεί από τον νόμο ως υποχρεωτική αργία. Στις

«Ο Θεοδωράκης είναι ένας κακός, αλλά πολύ επικίνδυνος σκηνοθέτης», αναφέρει ο «Ρουβίκωνας» σε ανάρτησή του στο Facebook.

Ξεχωρίζουν οι Λειψοί στα δημοσιεύματα των ξένων ΜΜΕ ανάμεσα στους Ελληνικούς προορισμούς που προωθούν το βιώσιμο τουρισμό. Η γερμανική
Συναγερμός έχει σημάνει στις ΗΠΑ για τον μύκητα Candida auris, που σκοτώνει έως και το 60% των ανθρώπων που μολύνει.

Τη ζωή του έχασε χθες το μεσημέρι (22/3) ο αρχισμηνίας και παίκτης του Πρωτέα Σχηματαρίου και της

Η Life at Sea Cruises εμπνεύστηκε την πρώτη κρουαζιέρα που θα διαρκέσει 3 χρόνια προσφέροντας στους ταξιδιώτες

Η 22α Μαρτίου του 2023 είναι η τριακοστή Παγκόσμια Ημέρα Νερού, η οποία αποφασίστηκε στον Οργανισμό Ηνωμένων

Παράσταση διαμαρτυρίας πραγματοποίησε σήμερα αντιπροσωπεία της Διοίκησης του Ε.Κ.Ρ με επικεφαλής τον Πρόεδρο, Εγγλέζο Παναγιώτη, το Γενικό

Ενημερώθηκε, πρωινές ώρες σήμερα, η Λιμενική Αρχή Λέρου για την ύπαρξη σορού άνδρα, σε προχωρημένη σήψη, αγνώστων